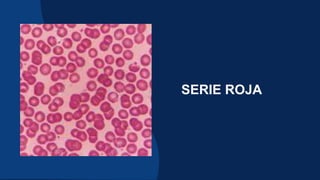
SERIE ROJA
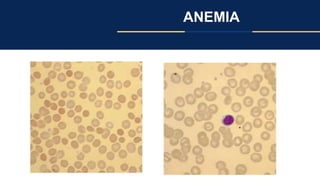
ANEMIA

Este documento trata sobre la semiología hematológica. Explica las bases fundamentales de la hematología y describe cómo se pueden presentar las hemopatías en función del tiempo (agudas o crónicas), los síntomas, los antecedentes familiares y personales del paciente, y los hallazgos en la exploración física como ganglios linfáticos, bazo, piel y boca. Además, detalla diversos síndromes hematológicos como diferentes tipos de anemia, leucemias, trastornos de la coag